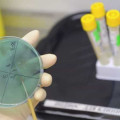

Լրահոս
 Իլինոյսում հրաձգության ժամանակ 6 մարդ է վիրավորվել
Իլինոյսում հրաձգության ժամանակ 6 մարդ է վիրավորվել
 Թուրքիայի տարածքում ամերիկյան անօդաչու թռչող սարք է ընկել
Թուրքիայի տարածքում ամերիկյան անօդաչու թռչող սարք է ընկել
 Ադրբեջանի ԱԱՆ ղեկավարի պաշտոնակատար է նշանակվել
Ադրբեջանի ԱԱՆ ղեկավարի պաշտոնակատար է նշանակվել
 Բելառուսը ՄԱԿ-ում ԵՏՄ-ին դիտորդի կարգավիճակ շնորհելու բանաձեւ է ներկայացրել
Բելառուսը ՄԱԿ-ում ԵՏՄ-ին դիտորդի կարգավիճակ շնորհելու բանաձեւ է ներկայացրել
 Խոլերայով 9 հազարից ավելի վարակվածների են հայտնաբերել Իրաքում, Տանզանիայում եւ Կոնգոյի ԴՀ-ում
Խոլերայով 9 հազարից ավելի վարակվածների են հայտնաբերել Իրաքում, Տանզանիայում եւ Կոնգոյի ԴՀ-ում
 ԿԺԴՀ-ի եւ Հարավային Կորեայի սահմանում սկսվել Է բաժանված ընտանիքների հանդիպումը
ԿԺԴՀ-ի եւ Հարավային Կորեայի սահմանում սկսվել Է բաժանված ընտանիքների հանդիպումը
 Հալեպի արվարձանների 35 հազար բնակիչ վերջին օրերին գաղթական է դարձել
Հալեպի արվարձանների 35 հազար բնակիչ վերջին օրերին գաղթական է դարձել
 Իսպանական duty free-ներն ամենաԷժանն են ճանաչվել Եվրոպայում
Իսպանական duty free-ներն ամենաԷժանն են ճանաչվել Եվրոպայում
 Եվրոպայի Հայ դատի հանձնախումբը Թուրքիայի խորհրդարանական ընտրություններում աջակցում է քրդամետ կուսակցությանը
Եվրոպայի Հայ դատի հանձնախումբը Թուրքիայի խորհրդարանական ընտրություններում աջակցում է քրդամետ կուսակցությանը
 Լոնդոնը 50 մլրդ դոլարի պարտավորագրեր Է կնքելու Պեկինի հետ Սի Ցզինպինի այցի ընթացքում
Լոնդոնը 50 մլրդ դոլարի պարտավորագրեր Է կնքելու Պեկինի հետ Սի Ցզինպինի այցի ընթացքում
 Կանադան օրհնված է, որ իր հասարակության մասն են կազմում նաև հայերը. Կանադայի Սենատի խոսնակ
Կանադան օրհնված է, որ իր հասարակության մասն են կազմում նաև հայերը. Կանադայի Սենատի խոսնակ
 Իրանական Արեւելյան Ատրպատական նահանգի ղեկավարը ժամանել է Ադրբեջան
Իրանական Արեւելյան Ատրպատական նահանգի ղեկավարը ժամանել է Ադրբեջան
 Հալեպում իրավիճակը վերջին օրերին ավելի հանգիստ է
Հալեպում իրավիճակը վերջին օրերին ավելի հանգիստ է
 ԻՊ-ի մարտիկները Սիրիայից փախչում են Թուրքիա
ԻՊ-ի մարտիկները Սիրիայից փախչում են Թուրքիա
 Տեխասցի պատանին, որին դպրոցում ահաբեկչի տեղ Էին դրել, Օբամայի հյուրն Է դարձել Սպիտակ տանը
Տեխասցի պատանին, որին դպրոցում ահաբեկչի տեղ Էին դրել, Օբամայի հյուրն Է դարձել Սպիտակ տանը
 Բաթումի նավահանգիստ Է մտել ամերիկյան «Փորթեր» Էսկադրային ականակիրը
Բաթումի նավահանգիստ Է մտել ամերիկյան «Փորթեր» Էսկադրային ականակիրը
 Ռուսական օդուժի ռմբակոծություններից Լաթաքիայում 45 մարդ է զոհվել
Ռուսական օդուժի ռմբակոծություններից Լաթաքիայում 45 մարդ է զոհվել
 Քայլար Միքայէլեանը նշանակվել է Ավստրալիայում ԼՂՀ մշտական ներկայացուցիչ
Քայլար Միքայէլեանը նշանակվել է Ավստրալիայում ԼՂՀ մշտական ներկայացուցիչ
 Իսրայելական ռետորանը զեղչեր է առաջարկում միևնույն սեղանի շուրջ նստող հրեաներին և արաբներին
Իսրայելական ռետորանը զեղչեր է առաջարկում միևնույն սեղանի շուրջ նստող հրեաներին և արաբներին
 Թբիլիսիում կայացավ Ցեղասպանության 100-րդ տարելիցին նվիրված ցուցահանդես
Թբիլիսիում կայացավ Ցեղասպանության 100-րդ տարելիցին նվիրված ցուցահանդես
 Ֆիլիպիններում մոլեգնող թայֆունի զոհերի թիվը հասել Է 22-ի
Ֆիլիպիններում մոլեգնող թայֆունի զոհերի թիվը հասել Է 22-ի
 Արամ Ա կաթողիկոսը հանդիպել է Հունաստանի նախագահի հետ
Արամ Ա կաթողիկոսը հանդիպել է Հունաստանի նախագահի հետ
 Բրյուսելում տեղի է ունեցել ՏՏ-ին նվիրված հայ-բելգիական համաժողով
Բրյուսելում տեղի է ունեցել ՏՏ-ին նվիրված հայ-բելգիական համաժողով
 Դիրաբեքիրի փաստաբանների ասոցիացիայի նախագահը ձերբակալվել է
Դիրաբեքիրի փաստաբանների ասոցիացիայի նախագահը ձերբակալվել է
 Կանադայում պահպանողականներն իշխանությունը զիջեցին լիբերալներին
Կանադայում պահպանողականներն իշխանությունը զիջեցին լիբերալներին
 Ինչո՞ւ Ադրբեջանում «գլխատեցին» ԿԳԲ-ի շեֆին
Ինչո՞ւ Ադրբեջանում «գլխատեցին» ԿԳԲ-ի շեֆին
 ԿԽՄԿ Արևելյան Եվրոպայի և Կենտրոնական Ասիայի տարածաշրջանային ղեկավարն այցելել է Արցախ
ԿԽՄԿ Արևելյան Եվրոպայի և Կենտրոնական Ասիայի տարածաշրջանային ղեկավարն այցելել է Արցախ
 ԱՄՆ-ի ռազմական մատակարարումների ծավալը հասել է 46,6 մլրդ ռեկորդային գումարի
ԱՄՆ-ի ռազմական մատակարարումների ծավալը հասել է 46,6 մլրդ ռեկորդային գումարի
 Ադրբեջանական նավթը դարձյալ էժանացել է
Ադրբեջանական նավթը դարձյալ էժանացել է
 Ադրբեջանը խզել է Ռուսաստանի հետ գազային պայմանագիրը
Ադրբեջանը խզել է Ռուսաստանի հետ գազային պայմանագիրը

 Երևանում կտեղադրվի Միսաք Մանուշյանի կիսանդրին
Երևանում կտեղադրվի Միսաք Մանուշյանի կիսանդրին
 Մենք չենք հրաժարվի նահատակների արյան համար վրեժխնդրությունից. Խամենեի
Մենք չենք հրաժարվի նահատակների արյան համար վրեժխնդրությունից. Խամենեի
 Նավթի գինը կրկին հասել է երեքանիշ մակարդակի
Նավթի գինը կրկին հասել է երեքանիշ մակարդակի
 ԱԺ ընտրություններից առաջ ճշգրտվում են ընտրողների ցուցակները
ԱԺ ընտրություններից առաջ ճշգրտվում են ընտրողների ցուցակները
 Ալի Լարիջանին պատասխանել է Թրամփին
Ալի Լարիջանին պատասխանել է Թրամփին
 Մադուրոն պահվում է ԱՄՆ բանտի պատժախցում․ ABC
Մադուրոն պահվում է ԱՄՆ բանտի պատժախցում․ ABC
 Իրանի գերագույն առաջնորդը հաստատել է իր կնոջ, քրոջ և նրա մանկահասակ երեխայի մահը
Իրանի գերագույն առաջնորդը հաստատել է իր կնոջ, քրոջ և նրա մանկահասակ երեխայի մահը
 Անվտանգ աշխատավայրը որպես զարգացման գրավական
Անվտանգ աշխատավայրը որպես զարգացման գրավական Մեր որոշումները կայացվում են ոչ թե էմոցիաներով, այլ սթափ հաշվարկներով․ Նաիրի Սարգսյան (տեսանյութ)
Մեր որոշումները կայացվում են ոչ թե էմոցիաներով, այլ սթափ հաշվարկներով․ Նաիրի Սարգսյան (տեսանյութ)
 Մարտուն Գրիգորյանի որդին ևս հաշիվ պահանջեց Վարդան Ղուկասյանի փեսայից
Մարտուն Գրիգորյանի որդին ևս հաշիվ պահանջեց Վարդան Ղուկասյանի փեսայից Մեր պահանջն է, որ բոլոր քաղբանտարկյալները լինեն ազատ. Թովմաս Առաքելյան
Մեր պահանջն է, որ բոլոր քաղբանտարկյալները լինեն ազատ. Թովմաս Առաքելյան ԶՊՄԿ-ն արձագանքում է Արամ Սարգսյանի հայտարարությանը
ԶՊՄԿ-ն արձագանքում է Արամ Սարգսյանի հայտարարությանը Ես վստահ եմ՝ դատավորները շատ լավ գիտեն, որ Սամվել Կարապետյանը լավից բացի, ոչ մի վատ բան չի արել իր հայրենիքի համար. Անաիս Սարդարյան
Ես վստահ եմ՝ դատավորները շատ լավ գիտեն, որ Սամվել Կարապետյանը լավից բացի, ոչ մի վատ բան չի արել իր հայրենիքի համար. Անաիս Սարդարյան Ցանկալի գնումներն՝ առանց երկար սպասելու
Ցանկալի գնումներն՝ առանց երկար սպասելու Ավերածություններ, կմախքի վերածված շենքեր, ամայացած փողոցներ. ինչ իրավիճակ է Լիբանանում
Ավերածություններ, կմախքի վերածված շենքեր, ամայացած փողոցներ. ինչ իրավիճակ է Լիբանանում
 ANCA-ն տեղեկացնում է, «մեղադրվողները»՝ հերքում. Մի սպառնալիքի հետքերով
ANCA-ն տեղեկացնում է, «մեղադրվողները»՝ հերքում. Մի սպառնալիքի հետքերով Փրկարարները, ջրասուզակները երկու օր է՝ ջրամբարում որոնում են 72–ամյա կնոջը. բարեկամներն այստեղ գտել են նրա գլխարկը
Փրկարարները, ջրասուզակները երկու օր է՝ ջրամբարում որոնում են 72–ամյա կնոջը. բարեկամներն այստեղ գտել են նրա գլխարկը
 Ազատություն Սամվել Կարապետյանին. Ռուբեն Մխիթարյան
Ազատություն Սամվել Կարապետյանին. Ռուբեն Մխիթարյան Իշխանության նոր սադրանքը գործի է դրվել
Իշխանության նոր սադրանքը գործի է դրվել Պատերազմի սկզբից ի վեր Իրանում տեղահանվել է մինչև 3.2 միլիոն մարդ
Պատերազմի սկզբից ի վեր Իրանում տեղահանվել է մինչև 3.2 միլիոն մարդ
 Թոշակառուները խնայում են լույսն ու գազը՝ կոպեկներ հետ ստանալու համար․ Հրայր Կամենդատյան
Թոշակառուները խնայում են լույսն ու գազը՝ կոպեկներ հետ ստանալու համար․ Հրայր Կամենդատյան Խախտել են մարդկային օրենքները եւ անխուսափելի պատժվելու են. Արմեն Աշոտյան
Խախտել են մարդկային օրենքները եւ անխուսափելի պատժվելու են. Արմեն Աշոտյան Դպրոցների փակումը միայն կրթական խնդիր չէ․ Ատոմ Մխիթարյան
Դպրոցների փակումը միայն կրթական խնդիր չէ․ Ատոմ Մխիթարյան Այս իշխանության օրոք Հայաստանը կորցրել է վստահելի դաշնակցի իր հեղինակությունը․ Ավետիք Չալաբյան
Այս իշխանության օրոք Հայաստանը կորցրել է վստահելի դաշնակցի իր հեղինակությունը․ Ավետիք Չալաբյան ԵՄ-ն չի թաքցնում իր նպատակները Հայաստանում
ԵՄ-ն չի թաքցնում իր նպատակները Հայաստանում Իշխանության ձեռքը սեղմողը և նրա հետ համագործակցողը չի կարող իրական ընդդիմադիր լինել․ Աննա Կոստանյան
Իշխանության ձեռքը սեղմողը և նրա հետ համագործակցողը չի կարող իրական ընդդիմադիր լինել․ Աննա Կոստանյան Հայաստանը կարող է ցանկացած պահի հայտնվել նոր պատերազմի կիզակետում․ Արեգ Սավգուլյան
Հայաստանը կարող է ցանկացած պահի հայտնվել նոր պատերազմի կիզակետում․ Արեգ Սավգուլյան Սարսափ ու խայտառակություն՝ Եվրոպական խորհրդարանի ամբիոնից
Սարսափ ու խայտառակություն՝ Եվրոպական խորհրդարանի ամբիոնից Սոցիալական ծրագիր 12/87. Տարեկան պարտադիր սկրինինգային հետազոտում. Հրայր Կամենդատյան
Սոցիալական ծրագիր 12/87. Տարեկան պարտադիր սկրինինգային հետազոտում. Հրայր Կամենդատյան Նախիջևանի օդանավակայանի վրա դրոնային հարձակումը ՄԱԿ-ի Անվտանգության խորհուրդը չի արձանագրել և չի դատապարտել. Էդմոն Մարուքյան
Նախիջևանի օդանավակայանի վրա դրոնային հարձակումը ՄԱԿ-ի Անվտանգության խորհուրդը չի արձանագրել և չի դատապարտել. Էդմոն Մարուքյան «Մեղվի և մեղվապահության» հյուրատունը Լոռու մարզում
«Մեղվի և մեղվապահության» հյուրատունը Լոռու մարզում Գարնանային ակցիա Մեգամոլում՝ Idram&IDBank-ից
Գարնանային ակցիա Մեգամոլում՝ Idram&IDBank-ից Ուժեղ Հայաստան կուսակցության նախագահ Սամվել Կարապետյանի ապօրինի դատավարությունն է, ու ես լինելու եմ վերոնշյալ հասցեում. Գառնիկ Դավթյան
Ուժեղ Հայաստան կուսակցության նախագահ Սամվել Կարապետյանի ապօրինի դատավարությունն է, ու ես լինելու եմ վերոնշյալ հասցեում. Գառնիկ Դավթյան Մինչ աշխարհը քննարկում է օրվա լուրերը, գերտերությունների ներկայացուցիչները դիվանագիտական խաղատախտակի վրա, աննկատ վերադասավորում են շախմատի խաղաքարերը. Արտակ Զաքարյան
Մինչ աշխարհը քննարկում է օրվա լուրերը, գերտերությունների ներկայացուցիչները դիվանագիտական խաղատախտակի վրա, աննկատ վերադասավորում են շախմատի խաղաքարերը. Արտակ Զաքարյան Շատ դժվար է ունենալ ազատ ընտրություններ, երբ Սամվել Կարապետյանը ազատազրկվել է խոսքի համար. Human Rights Watch-ի նախկին տնօրեն
Շատ դժվար է ունենալ ազատ ընտրություններ, երբ Սամվել Կարապետյանը ազատազրկվել է խոսքի համար. Human Rights Watch-ի նախկին տնօրեն Չի կարող մարդը լինել Հայ Առաքելական Եկեղեցու «հետևորդ» և ամենուրեք նույն եկեղեցուն պախարակել. Գագիկ Ասատրյան
Չի կարող մարդը լինել Հայ Առաքելական Եկեղեցու «հետևորդ» և ամենուրեք նույն եկեղեցուն պախարակել. Գագիկ Ասատրյան Բժիշկներն ամենասառնասիրտ ու անթույլատրելի ձևով են խոսում՝ հիվանդ երեխայի ծնողին ասելով. «հա դե, ուրիշ երեխա կունենաք». Աննա Հովհաննիսյան
Բժիշկներն ամենասառնասիրտ ու անթույլատրելի ձևով են խոսում՝ հիվանդ երեխայի ծնողին ասելով. «հա դե, ուրիշ երեխա կունենաք». Աննա Հովհաննիսյան Նիկոլ, Սահմանադրությունը դու չես փոխելու, որովհետև քո ուզած փոփոխությունը հայ ժողովրդի պահանջը չէ. Մենուա Սողոմոնյան
Նիկոլ, Սահմանադրությունը դու չես փոխելու, որովհետև քո ուզած փոփոխությունը հայ ժողովրդի պահանջը չէ. Մենուա Սողոմոնյան Ազատություն Սամվել Կարապետյանին. Նարեկ Սուքիասյան
Ազատություն Սամվել Կարապետյանին. Նարեկ Սուքիասյան Հաղթահարելով աղքատությունը՝ մենք հաղթում ենք մեր թշնամիներին. Նարեկ Կարապետյան. (տեսանյութ)
Հաղթահարելով աղքատությունը՝ մենք հաղթում ենք մեր թշնամիներին. Նարեկ Կարապետյան. (տեսանյութ) Վաղը Սամվել Կարապետյանի տնային կալանքից ազատելու դատն է. Նարեկ Կարապետյան
Վաղը Սամվել Կարապետյանի տնային կալանքից ազատելու դատն է. Նարեկ Կարապետյան Ինչո՞ւ են մարդիկ թունավոր ձուկ ուտում. «Փաստ»
Ինչո՞ւ են մարդիկ թունավոր ձուկ ուտում. «Փաստ» Սովորաբար սենց դեպքերում հարձակվում են տան տիրուհու վրա․ Փաշինյան
Սովորաբար սենց դեպքերում հարձակվում են տան տիրուհու վրա․ Փաշինյան
 Եվրոպացի ֆիզիկոսների կողմից կատարված հայտնագործությունը կօգնի բարձրացնել պերովսկիտային արևային մարտկոցների արդյունավետությունը
Եվրոպացի ֆիզիկոսների կողմից կատարված հայտնագործությունը կօգնի բարձրացնել պերովսկիտային արևային մարտկոցների արդյունավետությունը ՊԱՏՄՈՒԹՅԱՆ ԱՅՍ ՕՐԸ (12 ՄԱՐՏԻ). Աշխարհում առաջին ռադիոգիրը, ավտոմատ հեռախոսակայանի արտոնագրումը. «Փաստ»
ՊԱՏՄՈՒԹՅԱՆ ԱՅՍ ՕՐԸ (12 ՄԱՐՏԻ). Աշխարհում առաջին ռադիոգիրը, ավտոմատ հեռախոսակայանի արտոնագրումը. «Փաստ» Վաղը՝ մարտի 13-ին՝ ժամը 15:30-ին, լինելու եմ դատարանի դիմաց՝ աջակցելու Սամվել Կարապետյանին. Ալիկ Ալեքսանյան
Վաղը՝ մարտի 13-ին՝ ժամը 15:30-ին, լինելու եմ դատարանի դիմաց՝ աջակցելու Սամվել Կարապետյանին. Ալիկ Ալեքսանյան «Էպշտեյնի կոալիցիան» փորձում է Հարավային Կովկասի երկրները ներքաշել պատերազմական հորձանուտի մեջ. «Փաստ»
«Էպշտեյնի կոալիցիան» փորձում է Հարավային Կովկասի երկրները ներքաշել պատերազմական հորձանուտի մեջ. «Փաստ» Տղան մոր իրերի մեջ մի խորհրդավոր առարկա Է գտել և սարսափի մատնվել գրությունից
Տղան մոր իրերի մեջ մի խորհրդավոր առարկա Է գտել և սարսափի մատնվել գրությունից Ի՞նչ սադրանք են նախապատրաստում Հայաստանի իշխանությունները. «Փաստ»
Ի՞նչ սադրանք են նախապատրաստում Հայաստանի իշխանությունները. «Փաստ» Բացահայտվել է հակաբիոտիկների ընդունման անսպասելի հետևանք
Բացահայտվել է հակաբիոտիկների ընդունման անսպասելի հետևանք 





